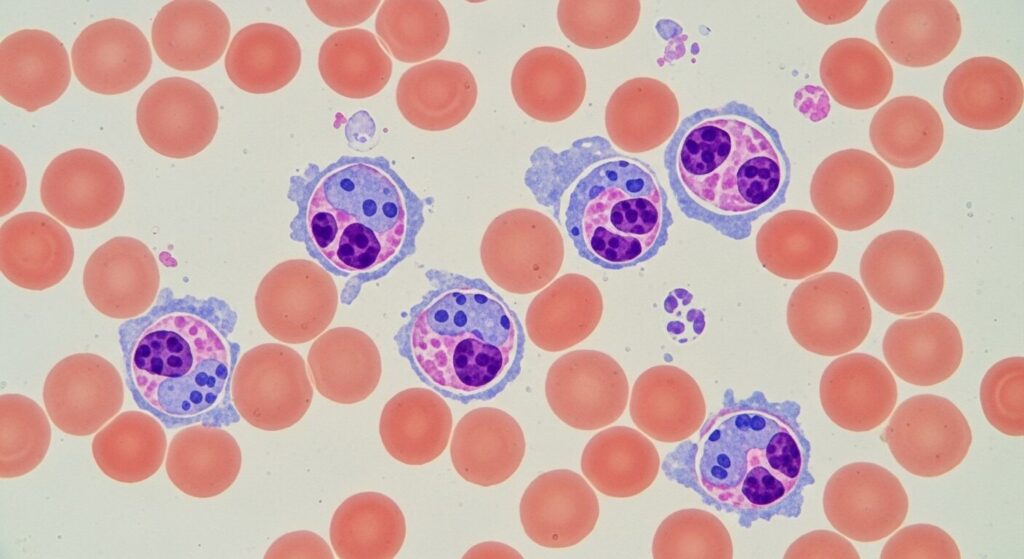

れいわ新選組の山本太郎代表が2025年1月21日、「血液のがんの一歩手前」にあることを公表し、参議院議員を辞職すると発表しました。
突然の発表に多くの人が驚き、山本太郎氏の病状や今後の活動について心配する声が広がっています。
この記事では、山本太郎氏が公表した血液のがんとは具体的にどんな病気なのか、そして今後の政治活動や復帰の可能性について詳しく解説していきます。
山本太郎の血液のがんとは多発性骨髄腫の一歩手前?
山本太郎代表(51歳)は、党のYouTubeチャンネルで「多発性骨髄腫、血液のがんの一歩手前にいる」と説明しました。
多発性骨髄腫とは、血液細胞の一つである形質細胞ががん化することで起こる血液のがんです。
山本氏の現在の状態は、医学的には「くすぶり型多発性骨髄腫(SMM)」または「意義不明の単クローン性ガンマグロブリン血症(MGUS)」の可能性があります。
これは多発性骨髄腫に進行する前の段階で、まだがんとして発症していない状態を指します。
山本氏は「進行させないことを最大のテーマに生きなければ、命を失いかねない」と語り、健康管理の重要性を強調しています。
また、「過度なストレスが最も大きな原因だろう」とも述べており、激務による身体への負担が病状に影響していることを示唆しました。
この発表を受けて、山本氏は参議院議員を辞職し、無期限の活動休止に入ることを決断しました。
ただし、れいわ新選組の代表職は続投するものの、業務量を大幅に削減する方針です。
山本太郎が公表した多発性骨髄腫とは?

多発性骨髄腫は、血液細胞の一つである形質細胞ががん化する血液のがんです。
発症率は10万人に約6人と比較的まれな疾患で、高齢になってから発症することが多い病気です。
主な症状としては、形質細胞ががん化すると異物を攻撃する能力がない「Mたんぱく」を産生し、腎機能の低下、貧血、発熱などが現れます。
病気の原因はまだよくわかっていませんが、ストレスや生活習慣が関係している可能性が指摘されています。
かつては治らない病気とされていましたが、この20年で治療法が大きく進歩しました。
分子標的薬など新しい薬が10種類以上登場し、現在では5年生存率が大幅に向上しています。
大阪医療センター血液内科の専門医によると、「薬を駆使して病気をコントロールできるようになってきた。症状が出ている人でも、働きながら治療を続けている人は多い」とのことです。
実際に、俳優の佐野史郎さんは2021年に発症後、2022年春に復帰を果たしています。
また、漫才師の宮川花子さんや経済学者の岸博幸氏など、多くの著名人が闘病し、社会復帰を果たしています。
このように、多発性骨髄腫は適切な治療を受けることで、コントロール可能な病気になってきているのです。
山本太郎の今後の活動や政界復帰の可能性は?

山本太郎氏は記者会見で「(国政への)復帰を目指す」と明言しており、政界引退は否定しています。
当面は治療に専念する方針ですが、病状が安定すれば政治活動への復帰を目指す意向を示しています。
現在の山本氏の状態は多発性骨髄腫の「一歩手前」であり、まだがんとして発症していない段階です。
この段階で適切な健康管理と治療を行えば、病気の進行を抑えることが十分に可能とされています。
山本氏自身も「進行させないことを最大のテーマに生きる」と語っており、病状管理に全力を注ぐ姿勢を見せています。
れいわ新選組の代表職は続投するものの、業務量を大幅に削減することで、身体への負担を軽減する方針です。
過度なストレスが病状の原因の一つと考えられているため、無理のない範囲での活動が重要になります。
他の著名人の例を見ても、適切な治療とストレス管理により、社会復帰を果たしている人は多くいます。
山本氏の政界復帰の可能性は十分にあると言えるでしょう。
まとめ
山本太郎氏が公表した血液のがんは、多発性骨髄腫の一歩手前の状態であり、まだがんとして発症していない段階です。
多発性骨髄腫は治療法が大きく進歩しており、適切な治療を受けることでコントロール可能な病気になっています。
山本氏は参議院議員を辞職し、無期限の活動休止に入りますが、国政への復帰を目指す意向を示しています。
今後は治療に専念し、病状を安定させることが最優先となりますが、適切な健康管理により政界復帰の可能性は十分にあると言えるでしょう。
山本太郎氏の一日も早い回復と、元気な姿での復帰を願っています。

コメント